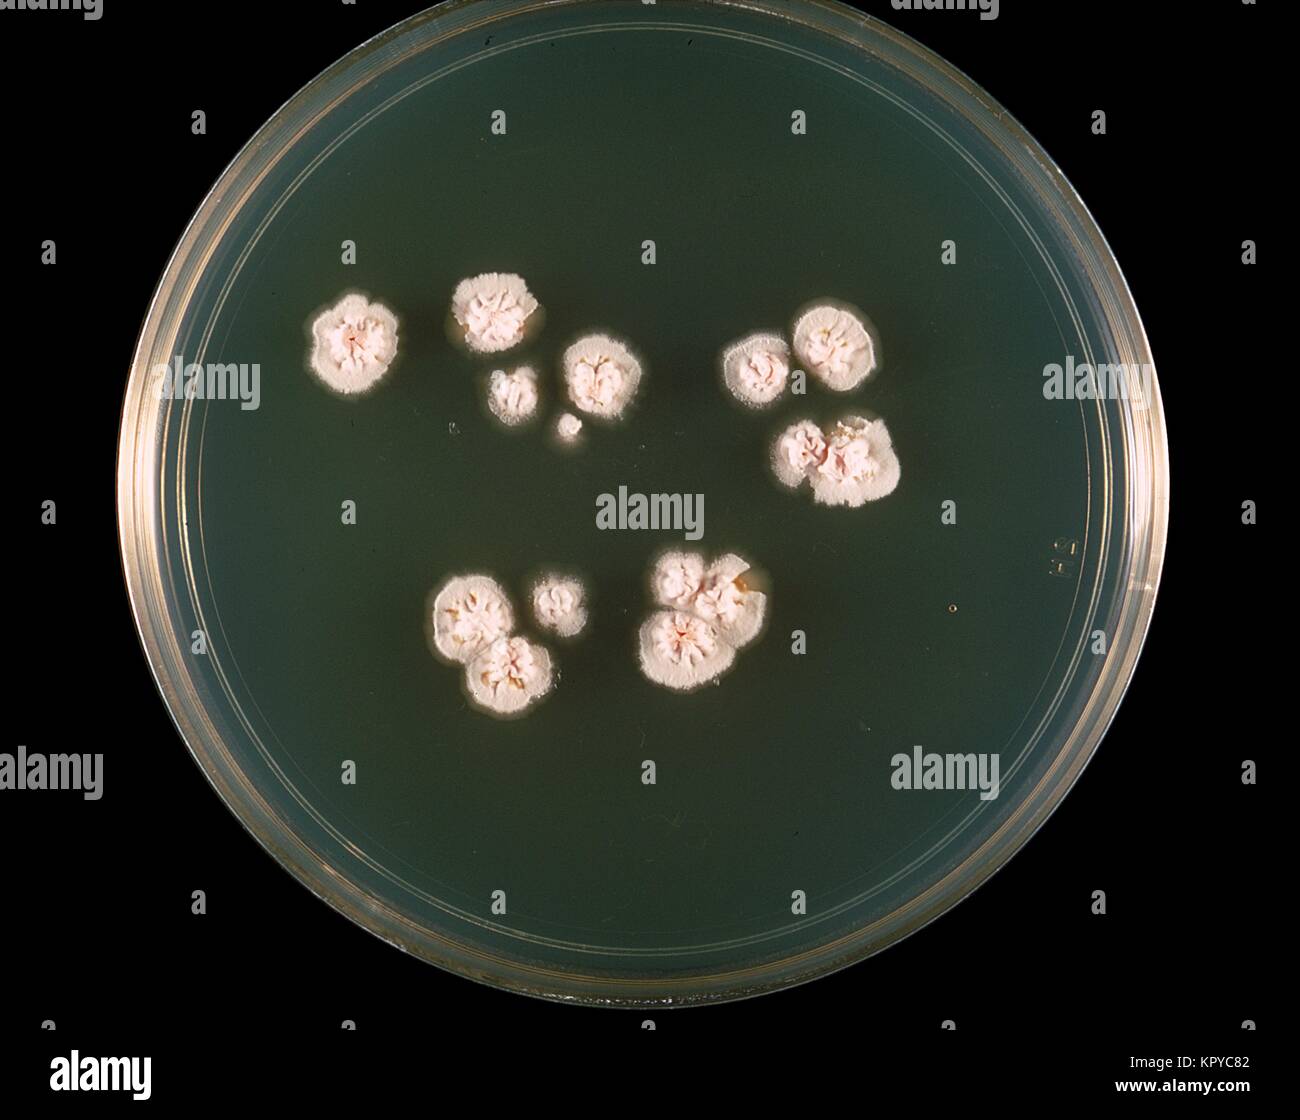
Nocardia bakterien Fotos und Bildmaterial in hoher Auflösung Alamy

Nocardia es un género de bacterias Gram-positivas que se encuentran en suelos de todo el mundo ricos en materia orgánica. Son Gram-positivas y con forma de bacilos filamentosos, parecen hilos alargados. Algunas especies son patogénicas que causan nocardiosis.[1] La mayoría de las infecciones causadas por Nocardia se adquieren por inhalación de la bacteria o a través de traumatismos.
Características
Nocardia es un género perteneciente al orden de los actinomicetales. Se diferencia de otras especies de actinomicetos mediante tinciones diferenciales para bacterias ácido-alcohol resistentes (BAAR).[2] Son bacilos aerobios estrictos, que forman hifas ramificadas o micelas en los tejidos y los cultivos, parecidas a las producidas por los hongos, por lo que por mucho tiempo se pensaba que eran hongos. Tienen una pared celular Gram-positiva, aunque se tiñen como si fueran Gram-negativas debido a que su pared celular es similar a la de las micobacterias.[3]
Cultivo
Las colonias de Nocardia presentan un aspecto variable, particularmente cuando crecen en un medio con nutrientes limitados. Crecen lentamente sobre medios de cultivo no selectivo, son estrictamente aerobios y tienen la facultad de crecer en un amplio rango de temperaturas. Algunas especies son parcialmente ácido-rápidas (en el sentido de que se necesita utilizar una solución menos concentrada de ácido sulfúrico o clorhídrico durante el procedimiento de tinción) debido a la presencia de ácidos micólicos de longitud intermedia en su pared celular.
La mayoría de las cepas poseen "factor de cordón" (6-6 dimicolato de trehalosa), un importante factor de virulencia. Son catalasa-positivas y pueden crecer fácilmente en los medios de cultivo más utilizados. Las colonias se hacen visibles en 3-5 días; sin embargo, a veces son necesarios prolongados períodos de incubación (2-3 semanas). El género incluye al menos 30 especies diferentes, de las cuales diez de ellas han sido aisladas de seres humanos.
Virulencia
Las distintas especies de Nocardia son bacterias patogénicas de baja virulencia; por lo cual solo son clínicamente significantes como infecciones oportunistas en sujetos de sistema inmune débil, tales como niños, ancianos y pacientes immunodeficientes. Los factores de virulencia nocardiales son las enzimas catalasa y superóxido dismutasa (que inactivan las especies reactivas del oxígeno que de otro modo serían tóxicas a la bacteria, además de un "factor de cordón" (que interfiere con la fagocitosis de los macrófagos evitando la fusión del fagosoma con el lisosoma).
Enfermedad y diagnóstico
Anteriormente se consideraba a Nocardia asteroides como el patógeno más común en el hombre, pero recientemente se ha descubierto que la mayoría de las cepas de esta bacteria estaban clasificadas erróneamente, y que Nocardia asteroides muy raramente podía asociarse a la enfermedad. Otras especies de interés médico son N. brasiliensis (Agente causal de la enfermedad en inmunocompetentes).[4] y N. otitidiscaviarum (antes N. caviae). La forma más común de enfermedad en los humanos es una neumonía de progresión lenta, cuyos síntomas comunes incluyen tos, disnea (dificultad para respirar) y fiebre. No es raro que esta infección se propague a la pleura o a la pared torácica. Enfermedades pulmonares preexistentes, especialmente la proteinosis alveolar pulmonar, aumentan el riesgo de contraer una neumonía nocardial. Todos los órganos pueden verse afectados si tiene lugar una propagación sistémica. En aproximadamente el 25-33 % de los pacientes la infección por Nocardia toma la forma de encefalitis y/o la formación de un absceso cerebral. También puede causar una gran variedad de infecciones cutáneas tales como el actinomicetoma (especialmente Nocardia brasiliensis), trastornos linfocutáneos, celulitis y abscesos subcutáneos.
El aislamiento de los especímenes biológicos se puede realizar utilizando como medio de cultivo el agar enriquecido con extracto de levadura y carbón activado (BCYE), el mismo utilizado para Legionella spp. También pueden emplearse medios selectivos para micobacterias u hongos. Los especímenes pueden obtenerse de esputos o, cuando es clínicamente necesario, del lavado broncoalveolar o de una biopsia. No se realizan rutinariamente pruebas bioquímicas para la identificación de las especies y no se dispone de pruebas cutáneas o serológicas.
Tratamiento
El tratamiento convencional es la terapia antibiótica con sulfonamida. La sulfonamida más comúnmente usada es trimetoprim-sulfametoxazol. Los pacientes que toman trimetoprim-sulfametoxazol por otras razones, por ejemplo, como prevención de infecciones de Pneumocystis jiroveci en sida, tienen pocas infecciones nocardiales. En casos refractarios pueden utilizarse dosis altas de imipenem y amikacina. La terapia antibiótica tiene que mantenerse por un período comprendido entre seis meses y un año. Un tratamiento cuidadoso de las heridas es también crítico.
Usos en biotecnología
La especie N. otitidis, ampliamente aislada de la tierra en todas partes del mundo, se ha comenzado a utilizar como productora de enzimas de restricción para su utilización en PCR, e ingeniería genética, utilizando el gen Notl que permite selectividad de sustratos modificados. NotI reconoce la secuencia 5'-GCGGCCGC-3' y genera fragmentos con términos cohesivos 5’. Además, pertenece a la clase de enzimas de corte infrecuente. Es una de las dos enzimas conocidas que reconoce secuencias octaméricas formadas solamente por residuos de C y G.[5]
Véase también
- Resistencia a los antibióticos
Referencias
Bibliografía adicional
- Ishikawa J, Yamashita A, Mikami Y, Hoshino Y, Kurita H, Hotta K, Shiba T, Hattori M (2004). «The complete genomic sequence of Nocardia farcinica IFM 10152». Proc Natl Acad Sci U S A 101 (41): 14925-30. PMID 15466710.
- Arceneaux, Jean. "Corynebacterium and Related Genera." Lecture to 2nd Year Medical Students at University of Mississippi Medical Center. 10/04/05.
- Greenwood, David, Richard C.B. Slack, and John F. Peutherer. Medical Microbiology: A Guide to Microbial Infections, 16th ed. (2002). ISBN 0-443-07077-6
Enlaces externos
- Genome sequence of N. farcinica IFM 10152
- MicrobeWiki's N. farcinica Page, Current as of June 2007